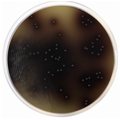
E-shop hlavní obrázek

Pro stanovení celkového počtu mikrobů v potravinách. Tento produkt je dodáván v dehydratované formě a je určen pro přípravu hotových kultivačních médií.

Selektivní a diferenciační médium pro detekci E.coli O157:H7. Tento produkt je dodáván v dehydratované formě a je určen pro přípravu hotových kultivačních médií.

Kultivační půda používaná pro izolaci, enumeraci a přímou identifikaci patogenů močových cest. Tento produkt je dodáván v dehydratované formě a je určen pro přípravu hotových kultivačních médií.

Kultivační půda používaná pro specifickou detekci a presumptivní identifikaci bakterií rodu Salmonella spp. ze vzorků stolice, potravin a vody. Tento produkt je dodáván v dehydratované formě a je určen pro přípravu hotových kultivačních médií.

Obohacené médium pro simultánní detekci celkového počtu koliformních organismů a počtu E. coli ve vodě, potravinách a mléčných produktech. Tento produkt je dodáván v dehydratované formě a je určen pro přípravu hotových kultivačních médií.

Selektivní médium pro současnou detekci E.coli a dalších koliformních bakterií ve vzorcích vody a potravin. Tento produkt je dodáván v dehydratované formě a je určen pro přípravu hotových kultivačních médií.

Pro detekci a rozlišení methicilin rezistentních Staphylococcus aureus a Staphylococcus epidermidis. Tento produkt je dodáván v dehydratované formě a je určen pro přípravu hotových kultivačních médií.

Chromogenní, selektivní a diferenciální půda navržená pro kvalitativní přímou detekci Staphylococcus aureus rezistetních k methicilinu (MRSA) z klinických vzorků. Tento produkt je dodáván v dehydratované formě a je určen pro přípravu hotových kultivačních médií.

Selektivní médium určené pro detekci a stanovení počtu Escherichia coli v potravinách. Tento produkt je dodáván v dehydratované formě a je určen pro přípravu hotových kultivačních médií.

Selektivní kultivační půda pro izolaci a stanovení počtu fekálních enterokoků přímou kultivací nebo membránovou filtrací.
Produkt je dodáván v dehydratované formě a je určen pro přípravu hotových kultivačních médií.

Pro identifikaci a potvrzení přítomnosti Pseudomonas spp. na základě produkce fluoresceinu.
Tento produkt je dodáván v dehydratované formě a je určen pro přípravu hotových kultivačních médií.

Médium pro identifikaci Pseudomonas spp. na základě produkce pyocyaninu. Tento produkt je dodáván v dehydratované formě a je určen pro přípravu hotových kultivačních médií.

Médium umožňující rozlišení gramnegativních enterobakterií na základě jejich schopnosti fermentovat laktózu a produkovat H2S.
Produkt je dodáván v dehydratované formě a je určen pro přípravu hotových kultivačních médií.
Pro izolaci a potvrzení střevních enterokoků v potravinách podle Mossela.
Produkt je dodáván v dehydratované formě a je určen pro přípravu hotových kultivačních médií.

Diferenciační médium umožňující rozlišení Escherichia coli a Enterobacter na základě jejich schopnosti využívat citrát.
Tento produkt je dodáván v dehydratované formě a je určen pro přípravu hotových kultivačních médií.

Reagens umožňující barevnou detekci mikrobiálního indolu.

Kultivační půda pro izolaci, kultivaci a detekci hemolytické aktivity náročných organismů. Tento produkt je dodáván v dehydratované formě a je určen pro přípravu hotových kultivačních médií.

Kultivační půda vhodná pro produkci chlamydospór Candida albicans a pro kultivaci fytopatologických hub. Tento produkt je dodáván v dehydratované formě a je určen pro přípravu hotových kultivačních médií.